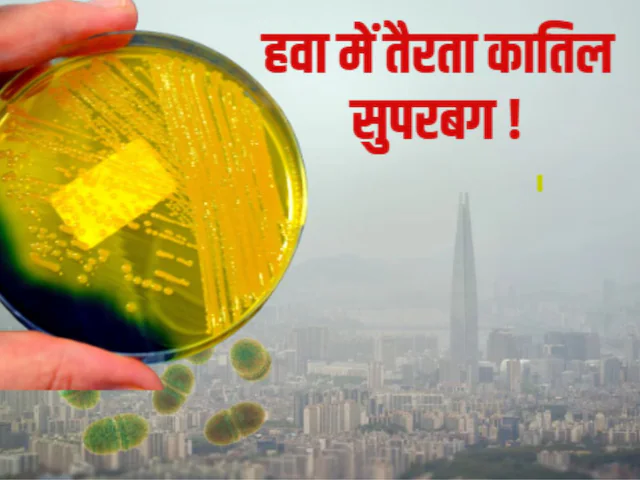
image

Shri S. Suresh Kumar Ji’s feat of cycling from Bengaluru to Kanniyakumari is commendable and inspiring. The...
Month: January 2026
PM to Inaugurate Grand International Exposition of Sacred Piprahwa Relics related to Bhagwan Buddha on 3rd January
The Prime Minister, Shri Narendra Modi, has conveyed his heartfelt greetings to the nation on the advent...
May the year ahead bring good health and prosperity, with success in your efforts and fulfilment in...
उत्तर भारत में इन दिनों घने कोहरे ने जनजीवन को बुरी तरह प्रभावित किया है. खासकर रेल...
ईवीएम पर हाहाकार मचाने वाले कांग्रेस नेता राहुल गांधी बुरी तरह फंसते दिख रहे हैं. राहुल गांधी...
इंदौर जैसे शहर में, जिसे देश का सबसे स्वच्छ शहर कहा जाता है, अगर नल से ज़हर...
बुलेट ट्रेन पर एक और बड़ी खुशखबरी आई है. मुंबई-अहमदाबाद बुलेट ट्रेन परियोजना में आज महाराष्ट्र ने...
दिल्ली की जहरीली हवा वैसे ही जहरीली है लेकिन अब इसमें ऐसे सुपरबग तैर रहे हैं जो...
हम उम्मीद करते हैं कि नया साल खुशियां लेकर आए लेकिन स्विट्जरलैंड के आलीशान आल्प्स रिजॉर्ट क्रैंस-मोंटाना...